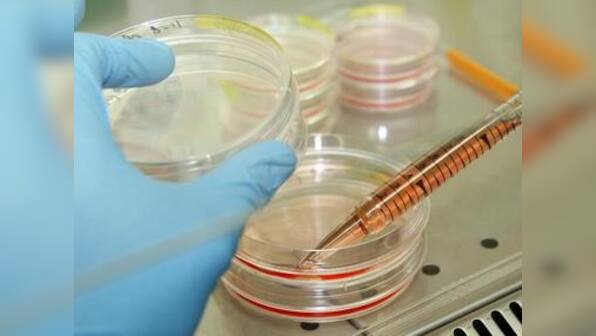

The Ministry of Health and Family Welfare, in a proposal to amend the Drugs and Cosmetics Act 1940, is pushing to bring stem cells and cell-based products under legal regulations: A move scientists have termed as long overdue. The ministry defined the category of stem cells and their derivatives that would be termed a drug, and would thereby have to follow the protocols mandated for any drug development, The Times of India reported. The notification, dated 4 April, said stem cells and products which are substantially altered, amounting to a change in biological characteristics, will be treated as a drug and will hence have to seek the regulator’s approval before coming to the market. The role of the
Central Drugs Standard Control Organisation (CDSCO), under the health ministry, will be central in this case. It is the national regulatory body for Indian pharmaceuticals and medical devices, and serves parallel function to the European Medicines Agency of the European Union, the PMDA of Japan, the Food and Drug Administration (FDA) of the United States and the Medicines and Healthcare products Regulatory Agency of the United Kingdom. In other words, CDSCO is responsible for regulating and licensing pharmaceuticals or new biological drug entities. Speaking to Firstpost over email, Deputy Director-General of the Indian Council of Medical Research (ICMR), Dr Geeta Jotwani, said that the notification was part of a review exercise by the CDSCO. “CDSCO was in process for comprehensive review of Drugs and Cosmetics Act, 1940, on the directions of Parliament. This is part of that exercise (that the) ministry/CDSCO has brought this amendment”, she said. [caption id=“attachment_3009680” align=“alignleft” width=“380”] Representational image. Reuters[/caption] Although ICMR has been at the forefront of the process bringing in regulations in stem cell use, and has compiled reports regarding guidelines for such research, the government body was reportedly not consulted by the ministry before the notification was sent out. Responding to these reports, Jotwani said, “ICMR will be reviewing and deliberating the draft notification in consultation with the experts in the field and also in light of
National Guidelines for Stem Cell Research-2017, which was released by Hon’ble Ministry of Health and Family Welfare. The recommendation or outcome of the same will be communicated to the ministry in due course”. Dr Sanjay Kumar, a senior researcher at the Centre for Stem Cell Research (CSCR), told Firstpost that government regulations in this sector are currently virtually absent, a fact taken advantage of by many who “milk the poor by settling on their own prices and practices”. The notification, however, does not touch upon the use of autologous stem cells, where the individual’s own stem cells are collected and minimally treated before infusing it back into the patient. “I think they will slowly rope in autologous stem cells into the regulations as well. There are some genuine cases where you can actually improve medical conditions of people by using autologous stem cells, going by what we observe at the centre. But not all people are ethical, scientifically or otherwise, and some want to make a quick buck: They are maligning the entire process. Sometimes, as scientists, we should also take part of the blame because we have hyped up the notion that everything can be cured by stem cells. Many of the patients are critically ill and desperate for medical treatment, and they are the ones who the crooks in the business target,” Kumar said. He added that government regulations will not hamper research. “Whichever institution has robust stem regulations usually have a strong IRB (institutional review board). In CSCR, 30 to40 people are present in every IRB meeting. So regulation does happen in different capacities even now, and are absolutely necessary too. Regulations will not come in the way of research in any way: Now the process will be a little longer but that’s alright because every institution needs to have regulations,” he said. Regulations around the world Having worked in several countries for his research, Kumar says India is one of the only nations yet to bring in regulations for use of stem cells. “The United States is the strictest in this regard and has multiple stages of regulations in place. All advanced countries already have strict regulations in place, except India and China,” he said. In the United States, FDA’s Center for Biologics Evaluation and Research
regulates human cells, tissues, and cellular and tissue-based products intended for implantation, transplantation, infusion or transfer into a human recipient, including hematopoietic stem cells. A
National Library of Medicine report says that China has one of the most unrestrictive stem cell policies in the world. In Japan, while the government allows scientists to conduct stem cell research for therapeutic purposes, there are no formal guidelines. South Korea‘s reputation as a leader in stem cell research suffered a blow in 2006 when it was discovered that the country’s leading biomedical researcher, Dr Hwang Woo-suk, falsely claimed that he was the first scientist to clone human embryonic stem cells for the purpose of clinical trials, a
Pew Research Centre report stated. Despite the scandal, the South Korean government continues to promote therapeutic cloning for stem cell research, although reproductive cloning is forbidden. The report added that Germany has one of the most restrictive policies for human embryonic stem cell research, due in part to the history of unethical medical experiments conducted by the Nazi regime during World War II. However, in April 2008, German Parliament authorised the use of imported stem cell lines produced before 1 May, 2007, to better facilitate the study of stem cell therapy. While Mexico has a
flourishing stem cell industry, it does not have formal regulations, a fact criticised by the international community. Mexican doctors currently use stem cells to treat foreign patients, including Americans, who suffer from ailments such as cerebral palsy, autism, and paralysis.
The health ministry , in a proposal to amend existing rules, pushed to bring stem cells and cell-based products under legal regulations
Advertisement
End of Article

)

)
)
)
)
)
)
)
)



